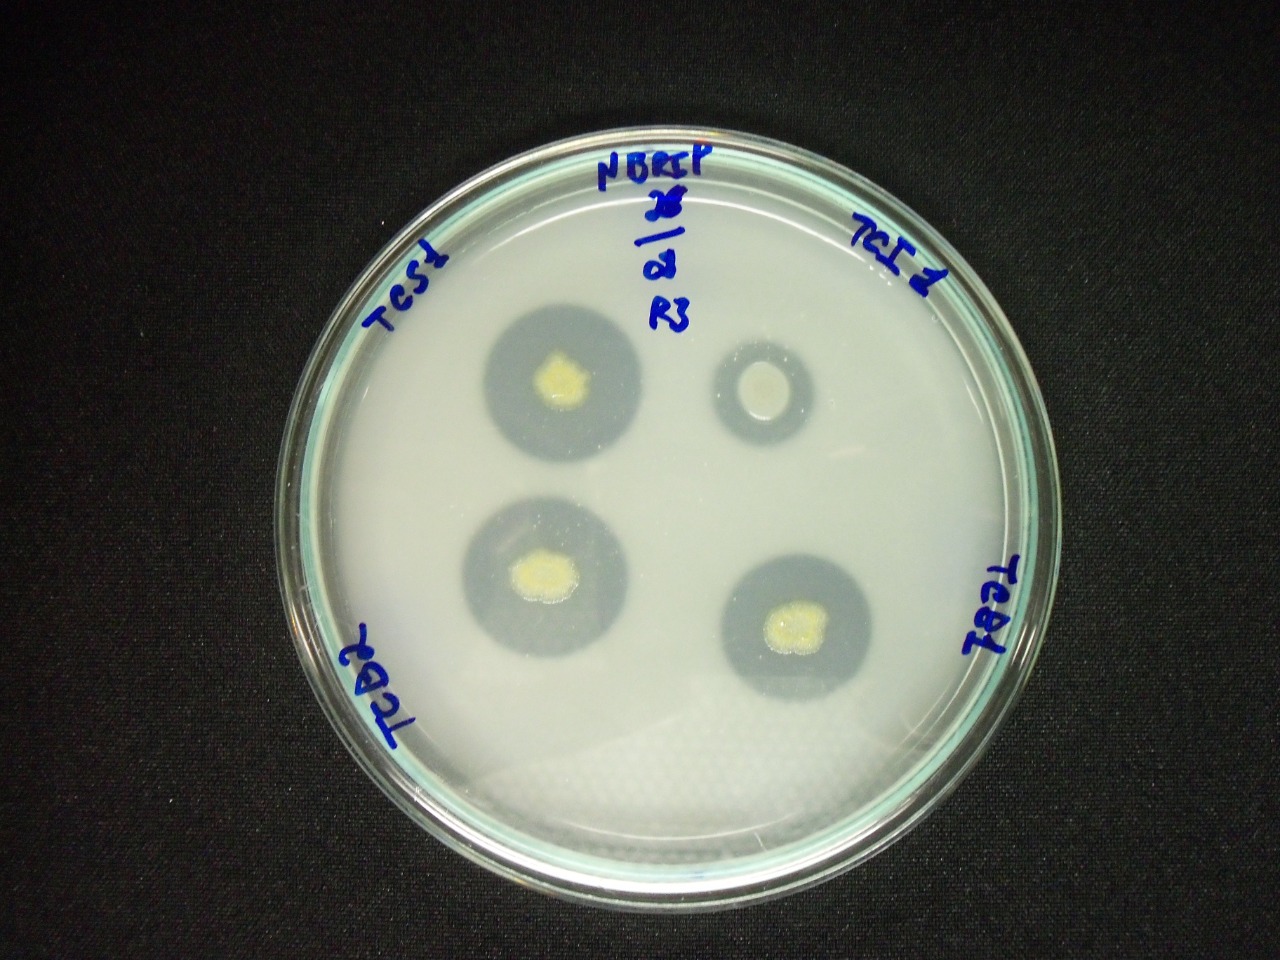

Notícias
Startup da UFPB avança no desenvolvimento de bioinsumo para agronegócio

A startup da Universidade Federal da Paraíba (UFPB) YBY Inovações Biotecnológicas está desenvolvendo um novo tipo de bioinsumo com tecnologia inovadora. A empresa é especializada na produção de inoculante biológico inédito com bactérias promotoras de crescimento para plantas que se destacam no agronegócio do Nordeste brasileiro.
Os bioinsumos são produtos biológicos que buscam contribuir para um sistema de produção sustentável. Desde 2020, a empresa tem dedicado esforços para o desenvolvimento de um novo bioinsumo com bactérias promotoras de crescimento para cana-de-açúcar e outras plantas gramíneas, que deve ser inserido no mercado nos próximos anos.

Coordenada pelo Prof. Cosme Martinez Salinas, do Centro de Ciências Exatas e da Natureza (CCEN), a YBY também presta serviço de consultoria em tecnologias e serviços de análises biológicas de solos e tecidos vegetais para implementação de sistemas orgânicos de baixa emissão de poluentes.
“A pesquisa básica continua de modo indissociado do estudo tecnológico com a parceria da UFPB. Temos identificado bactérias com maior potencial de promoção de crescimento e minimização dos efeitos do estresse hídrico em variedades de cana-de-açúcar utilizadas na região Nordeste”, comentou o coordenador da YBY.

De acordo com o Prof. Cosme, os resultados são bastante promissores e já existe a pretensão de iniciação da fase mais ampla de experimentos de campo para a avaliação em culturas agrícolas do agronegócio estadual, em parceria com empresas interessadas em novos bioinsumos para seus sistemas produtivos.
O diferencial inovativo da empresa está na utilização de bactérias inéditas com múltiplos atributos promotores de crescimento de plantas. Segundo o coordenador, o atual contexto do agronegócio no Brasil depende, em alto nível, da importação de fertilizantes.
Por esse motivo a utilização destes microrganismos seria estratégica, tendo em vista a capacidade verificada de fixar o nitrogênio atmosférico, solubilizar minerais do solo e produzir hormônios vegetais estimuladores de crescimento, com elevado potencial para a redução da demanda de fertilizantes nas culturas agrícolas, alvo de forte impacto socioambiental.
“As bactérias são oriundas da bioprospecção da biodiversidade do Nordeste e, consequentemente, adaptadas às condições edafoclimáticas da região”, comentou o docente.
Para o Prof. Cosme, editais de concorrência nacional, encontros com representantes da indústria do bioinsumos e investidores de risco interessados nas atividades da YBY Inovações Biotecnológicas têm contribuído significativamente no amadurecimento estratégico da empresa e no fortalecimento do empreendimento.
O empreendimento foi criado em junho de 2020. Em dezembro do ano passado, a startup foi uma das três primeiras que assinaram contrato de incubação com a UFPB dentro do Programa de Incubação de Empresas de Base Tecnológica da Inova-UFPB. Atualmente, a empresa está em processo de instalação nas dependências do Laboratório de Bioprocessos e Bioprodutos, do Departamento de Química.

Outras atividades da startup da UFPB incluem estudos de mercado, análises de tecnologias alternativas, contato com potenciais clientes (usuários finais, biofábricas e investidores), além da participação em capacitações e ecossistemas de empreendedorismo.
“A criação surgiu juntamente com a oportunidade, pois já existia o interesse por parte da equipe na UFPB de avançar com os trabalhos acadêmicos para o nível tecnológico, que é o objetivo deste empreendimento, dando retorno à sociedade na forma de um produto e serviço inovador”, pontuou o Prof. Cosme.
